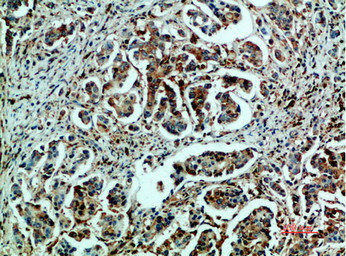

-
中文名稱:HSPA5兔多克隆抗體
-
貨號:CSB-PA873500
-
規格:¥1090
-
圖片:
-
Western blot analysis of 3T3 Cell Lysate, antibody was diluted at 1:1000
-
Immunohistochemical analysis of paraffin-embedded human-breast-cancer, antibody was diluted at 1:200
-
Immunohistochemical analysis of paraffin-embedded human-breast-cancer, antibody was diluted at 1:200
-
Immunohistochemical analysis of paraffin-embedded human-colon-cancer, antibody was diluted at 1:200
-
Immunohistochemical analysis of paraffin-embedded human-colon-cancer, antibody was diluted at 1:200
-
-
其他:
產品詳情
-
Uniprot No.:
-
基因名:
-
別名:78 kDa glucose regulated protein antibody; 78 kDa glucose-regulated protein antibody; AL022860 antibody; AU019543 antibody; BIP antibody; D2Wsu141e antibody; D2Wsu17e antibody; Endoplasmic reticulum lumenal Ca(2+)-binding protein grp78 antibody; Endoplasmic reticulum lumenal Ca2+ binding protein grp78 antibody; Epididymis secretory sperm binding protein Li 89n antibody; FLJ26106 antibody; Glucose Regulated Protein 78 antibody; Glucose Regulated Protein 78kDa antibody; GRP 78 antibody; GRP-78 antibody; GRP78 antibody; GRP78_HUMAN antibody; Heat shock 70 kDa protein 5 antibody; Heat Shock 70kDa Protein 5 antibody; Heat shock protein family A (Hsp70) member 5 antibody; HEL S 89n antibody; Hsce70 antibody; HSPA 5 antibody; HSPA5 antibody; Immunoglobulin Heavy Chain Binding Protein antibody; Immunoglobulin heavy chain-binding protein antibody; mBiP antibody; MIF2 antibody; Sez7 antibody
-
宿主:Rabbit
-
反應種屬:Human,Mouse,Rat
-
免疫原:Synthetic peptide from Human protein at AA range: 1268-1341
-
免疫原種屬:Homo sapiens (Human)
-
標記方式:Non-conjugated
-
純化方式:The antibody was affinity-purified from rabbit serum by affinity-chromatography using specific immunogen.
-
濃度:It differs from different batches. Please contact us to confirm it.
-
保存緩沖液:Liquid in PBS containing 50% glycerol, 0.5% BSA and 0.02% sodium azide.
-
產品提供形式:Liquid
-
應用范圍:WB,IHC,ELISA
-
推薦稀釋比:
Application Recommended Dilution WB 1:500-1:2000 IHC IHC-p:1:50-1:300 ELISA 1:5000-1:20000 -
Protocols:
-
儲存條件:Upon receipt, store at -20°C or -80°C. Avoid repeated freeze.
-
貨期:Basically, we can dispatch the products out in 1-3 working days after receiving your orders. Delivery time maybe differs from different purchasing way or location, please kindly consult your local distributors for specific delivery time.
-
用途:For Research Use Only. Not for use in diagnostic or therapeutic procedures.
引用文獻
- Chronic Exposure to Bisphenol S Impairs Hepatic Mitochondrial Dynamics, Induces Endoplasmic Reticulum Stress, and Worsens Metabolism in Diet-Induced Obesity Male Mice E Barreto-Reis, V Sepúlveda-Fragoso, LG Diniz,SSRN,/
- ER stress improvement by aerobic training or enalapril differently ameliorates pathological cardiac remodeling in obese mice ACP Salles,Molecular and Cellular Biochemistry,2024
相關產品
靶點詳情
-
功能:Endoplasmic reticulum chaperone that plays a key role in protein folding and quality control in the endoplasmic reticulum lumen. Involved in the correct folding of proteins and degradation of misfolded proteins via its interaction with DNAJC10/ERdj5, probably to facilitate the release of DNAJC10/ERdj5 from its substrate. Acts as a key repressor of the ERN1/IRE1-mediated unfolded protein response (UPR). In the unstressed endoplasmic reticulum, recruited by DNAJB9/ERdj4 to the luminal region of ERN1/IRE1, leading to disrupt the dimerization of ERN1/IRE1, thereby inactivating ERN1/IRE1. Accumulation of misfolded protein in the endoplasmic reticulum causes release of HSPA5/BiP from ERN1/IRE1, allowing homodimerization and subsequent activation of ERN1/IRE1. Plays an auxiliary role in post-translational transport of small presecretory proteins across endoplasmic reticulum (ER). May function as an allosteric modulator for SEC61 channel-forming translocon complex, likely cooperating with SEC62 to enable the productive insertion of these precursors into SEC61 channel. Appears to specifically regulate translocation of precursors having inhibitory residues in their mature region that weaken channel gating. May also play a role in apoptosis and cell proliferation.; (Microbial infection) Plays an important role in viral binding to the host cell membrane and entry for several flaviruses such as Dengue virus, Zika virus and Japanese encephalitis virus. Acts as a component of the cellular receptor for Dengue virus serotype 2/DENV-2 on human liver cells.; (Microbial infection) Acts as a receptor for CotH proteins expressed by fungi of the order mucorales, the causative agent of mucormycosis, which plays an important role in epithelial cell invasion by the fungi. Acts as a receptor for R.delemar CotH3 in nasal epithelial cells, which may be an early step in rhinoorbital/cerebral mucormycosis (RCM) disease progression.
-
基因功能參考文獻:
- the in-vitro anti-proliferative and pro-apoptotic effects in colorectal cancer cells that were induced by silencing cell migration inducing hyaluronan binding protein may be associated with GRP78 repression and UPR attenuation PMID: 29024602
- Cell surface GRP78 promotes cancer stemness, whereas drives cells toward a non-stemlike phenotype when it chaperones Progranulin. PMID: 29323121
- We showed that GRP78 is elevated in diabetic macular edema patients. In addition, there is a correlation between GRP78 and VEGF levels in aqueous humor. However, GRP78 levels were not associated with the responsiveness of anti-VEGF in diabetic macular edema patients. PMID: 30407281
- Data suggest that prostatic tumor GRP78 expression correlates with disease stage; anti-GRP78 autoantibody levels parallel prostate-specific antigen concentrations in patient-derived serum samples. PMID: 29066620
- High GRP78 expression is associated with radioresistance in nasopharyngeal carcinoma. PMID: 30015969
- Data suggest a complex but functional interplay of ER chaperone GRP78 and steroid hormones, working together for cell survival and proliferation in the context of reproduction. PMID: 29932125
- the physiological role played by the complex KCTD15-GRP78 in the adipogenesis PMID: 29665387
- Concomitant high expression of ERalpha36, GRP78 and GRP94 is associated with aggressive papillary thyroid cancer behavior and may be used as a predictor for extrathyroid extension, lymph node metastasis, and distant metastasis. PMID: 29368272
- We found that downregulation of GRP78 led to inhibition of autophagy, cell cycle arrest in the G0/G1 phase, and activation of caspase-7-induced apoptosis, and this was affected by the initial autophagy level. PMID: 29749510
- GRP78 promotes cigarette smoke-induced inflammatory response and mucus hyperproduction in airway epithelial cells, likely through upregulation of necroptosis and subsequent activation of NF-kappaB and AP-1 pathways. PMID: 29445274
- Data suggested that GRP78 silencing increased chemo-sensitivity and improved the effects of cisplatin-induced apoptosis in SiHa cells. Moreover, inhibition of GRP78 could upregulate caspase-3 and CHOP expression and downregulate Bcl-2 expression. PMID: 29650944
- Upon IgM expression, its levels temporarily eclipse those of the endoplasmic reticulum chaperone BiP, leading to acute, full-geared unfolded protein response activation. Once BiP is in excess again, the unfolded protein response transitions to chronic, submaximal activation, indicating that the unfolded protein response senses endoplasmic reticulum stress in a ratiometric fashion. PMID: 29251598
- GRP78 binds to and acts in concert with a glycosylphosphatidylinositol-anchored protein, CD109, in blocking TGF-beta signaling by promoting the routing of the TGF-beta receptor to the caveolae, thereby disrupting its binding to and activation of Smad2. PMID: 29654145
- this study demonstrates the reaction of placental GRP78 with sera from women with multiple sclerosis PMID: 29276183
- This meta-analysis shows that BiP or anti-BiP antibodies have a moderate accuracy for the diagnosis of rheumatoid arthritis with a moderate sensitivity and high specificity. It can be an efficient supplement to the existing diagnostic method. [Meta-Analysis] PMID: 29185956
- the expression of three cytokines for the pathogenesis of osteoarthritis (OA). which include IL-1beta, MMP14 and GRP78 was decreased by the various concentrations of icariin. These preliminary results imply that icariin might be an effective compound for the treatment of OA disease. PMID: 29292760
- In a retrospective cervical cancer cohort, high GRP78 expression was correlated with poor survival. miR-181a suppressed cervical cancer development via downregulating GRP78. PMID: 28245171
- We revealed that DAL-1 was downregulated while HSPA5 was upregulated in NSCLC and found the protein of DAL-1 and HSPA5 co-localized in the cytoplasm and nucleus. We demonstrated that DAL-1 can suppress the expression of HSPA5 on mRNA and protein levels, and decrease EMT, migration, invasion and proliferation abilities by down-regulating HSPA5 PMID: 29048640
- We found that inhibiting the function of surface GRP78 suppressed cancer cell survival and growth proving that the surface-expressed GRP78 is a vital receptor involved in the proliferation of high-grade glioma. PMID: 27713511
- BiP/GRP78 is significantly associated with tumor aggressiveness and progression. The increased expression of BiP/GRP78 was identified as an independent factor for predicting poor OS in patients with early stage of disease. PMID: 28854502
- GRP78 overexpression decreased advanced glycation end product levels and rescued the cells from Ribosome-induced cytotoxicity. PMID: 29410209
- This study established a macrophage polarization model with human monocytes and found that the conditioned medium from M2 macrophages increased GRP78 expression in tumor cells and facilitated tumor cell migration. PMID: 28629783
- GRP78 silencing promoted lung epithelial cell apoptosis during hyperoxia, via regulation of the CHOP pathway. PMID: 28586043
- GRP78 role in dengue virus infection. PMID: 27779201
- Overexpression of GRP78 is a novel predictor of favorable outcomes in patients with advanced thymic carcinoma. who receive combination chemotherapy. PMID: 28550415
- GRP78 is an autoantigen that could stimulate autoimmune responses and serve as a potential marker for recurrent and metastatic progression in HCC. PMID: 28186997
- These results identify GRP78 antibodies as a potential component of Neuromyelitis optica pathogenesis. PMID: 28679661
- HSPA5 (GRP78) and GEP were identified to interact. Clinical analysis showed that expression of GRP78 was up-regulated in hepatocellular carcinoma tumor and correlated with GEP expression. PMID: 28601093
- an endoplasmic reticulum complex of resident chaperones that includes HSP47, FKBP65, and BiP regulating the activity of LH2. PMID: 28177155
- The present study indicates that GRP78 is increased in BALF in cigarette smokers; that HAEC secrete GRP78; and that GRP78 secretion by HAEC is augmented by cigarette smoke particulates. Enhanced secretion of GRP78 by lung cells makes it a potential biomarker of cigarette smoke-induced lung injury. PMID: 28464871
- P4HB promotes hepatocellular carcinoma progression by down-regulating GRP78 expression and subsequently promoting epithelial-to-mesenchymal transition. PMID: 28052026
- analysis of the effects of triptolide on cell proliferation, cell cycle and the expression of GRP78 in nasopharyngeal carcinoma PMID: 27391061
- Antibodies targeting GRP78 exhibited antitumor activity and enhanced the efficacy of radiation in Non-small cell lung cancer and glioblastoma multiforme both in vitro and in vivo GRP78 is a promising novel target, and anti-GRP78 antibodies could be used as an effective cancer therapy alone or in combination with ionizing radiation PMID: 27815359
- Novel finding of the current study is that the level of GRP78/BiP was greatly increased in the Parkinson's disease dementia and dementia with Lewy bodies patients compared with people with Alzheimer's disease in cingulate gyrus and parietal cortex. PMID: 26202523
- Bisdemethoxycurcumin promotes apoptosis through a GRP78-dependent pathway and mitochondrial dysfunctions, and potentiates the antitumor effect of gemcitabine in human pancreatic cancer cells. PMID: 27845899
- Results identified GRP78 and HSP90a as binding partners of PRDM14 in triple-negative breast cancer cells, and all participate in cancer regulation. The interactions were direct and required the C-terminal region including the zinc finger motifs of PRDM14. PMID: 29178343
- GRP78 affects p53 localization which in turn regulates autophagy. PMID: 27814589
- candidate genes that modulate Hspa5 expression in the retina, were examined. PMID: 27881906
- Overexpression or knockdown demonstrated that GRP78 promoted proliferation and anti-apoptosis of clear cell renal cell carcinoma cells, and the oncogenic activity of GRP78 resulting in by miR-30a-5p overexpression. PMID: 29073630
- this study provided mechanistic evidences to support the positive regulatory function of FOXM1 in HSPA5 expression in colorectal cancer PMID: 27034162
- Cancer-associated fibroblasts induced GRP78 expression in A549 and SPCA-1 cells to facilitate Non-Small Cell Lung Cancer cell migration and invasion PMID: 27016417
- results suggest that the cooperative effects of radiotherapy and cetuximab could be further improved by inhibiting GRP78 in non-responsive oropharyngeal carcinoma patients PMID: 29232380
- Study reports that the endoplasmic reticulum luminal co-chaperone ERdj4/DNAJB9 is a selective IRE1 repressor that promotes a complex between the luminal Hsp70 BiP and the luminal stress-sensing domain of IRE1alpha. PMID: 29198525
- GRP78 role in the resistance to cisplatin in the nasopharyngeal carcinoma cells. PMID: 27254284
- High expression of GRP78 is associated with nonalcoholic steatohepatitis. PMID: 28951310
- Data show that cancer-associated fibroblasts (CAFs)-derived hepatocyte growth factor (HGF) or recombinant HGF activated c-Met/phosphoinositide 3-kinase (PI3K)/Akt and glucose-regulated protein 78 (GRP78) signalling pathways in ovarian cancer cells. PMID: 28258248
- HSPA5/BIP has roles in endoplasmic reticulum stress, autophagy and apoptosis; inhibitors of HSPA5 could be useful in cancer treatment PMID: 27791469
- Immunohistochemical analysis showed that STAT3, GRP78 and BAX protein levels in the combination group were significantly higher than those in STAT3 group and CDDP group (P<0.05). Exogenous STAT3 and CDDP may synergistically inhibit the xenograft tumour growth through up-regulation of BAX protein via GRP78. PMID: 27129294
- GRP78 inhibition enhances ATF4-induced cell death by the deubiquitination and stabilization of CHOP in human osteosarcoma cells. PMID: 28947141
- the chaperone 78-kDa glucose-regulated protein (GRP78) protects the MPD against PDI-dependent disulfide-bond isomerization by binding to this domain and, thereby, preventing ADAM17 inhibition. PMID: 28949004
顯示更多
收起更多
-
相關疾病:Autoantigen in rheumatoid arthritis.
-
亞細胞定位:Endoplasmic reticulum lumen. Melanosome. Cytoplasm. Cell surface.
-
蛋白家族:Heat shock protein 70 family
-
數據庫鏈接:
Most popular with customers
-
-
YWHAB Recombinant Monoclonal Antibody
Applications: ELISA, WB, IHC, IF, FC
Species Reactivity: Human, Mouse, Rat
-
Phospho-YAP1 (S127) Recombinant Monoclonal Antibody
Applications: ELISA, WB, IHC
Species Reactivity: Human
-
-
-
-
-